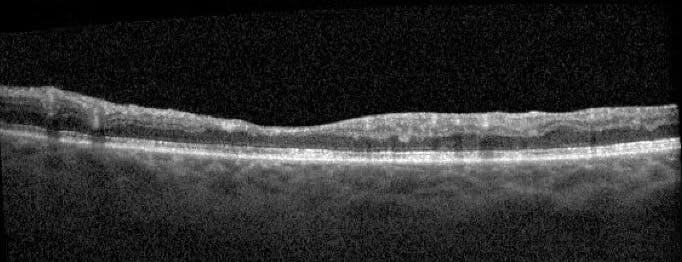
<p>Figure 6. OCT inferior to the fovea showed significant retinal thinning in a 55-year-old patient who presented with 20/100 VA. Still, I was unable differentiate between BRAO versus BRVO by OCT imaging alone.</p>

Introduction
Many of us first heard about OCT angiography (OCTA) on the podium at a retina conference many years ago, probably in the context of a clinical trial or from a retina researcher with a specific passion for imaging’s potential to unveil the complexities of ocular anatomy. At that time, it was a powerful research modality, but it was far from a routine clinical tool.
But times have changed, and the proliferation of OCTA platforms across retina clinics means that more providers than ever have access to this powerful technology. In the interest of sharing our experiences with OCTA with our colleagues, we sat down to record two conversations on the podcast New Retina Radio; you may access the episodes via the pair of QR codes herein. During our discussions, we showed how we applied OCTA in real-world cases within our clinics, and how we used those cases as a starting point to have a larger conversation about the powers and limitations of OCTA in 2025.
The transcripts below are edited for clarity and brevity, but they offer a snippet of our discussions. If you’re curious to learn more about how OCTA can elevate your practice, listen to our full conversations on New Retina Radio after digesting these brief previews.
—Yasha Modi, MD, and Katherine Talcott, MD
OCTA in Practice: Exploring Its Role in Retinal Disease Management
Yasha Modi, MD, and Katherine Talcott, MD
Katherine Talcott, MD: A 45-year-old phakic man with a history of central serous retinopathy (CSR) presented to the clinic. An EMR review found that 1 year prior to his presentation, his visual acuity OU was 20/20; according to the patient, he had “been followed for drusen” for the past 10 years. Further inquiry unveiled a remote history of photodynamic therapy in his right eye, and a previously trialing of eplerenone (Inspira; Pfizer) that did not result in fluid resolution. OCT imaging OD from 1 year prior to presentation in my clinic showed no subretinal fluid, but some subtle central retinal pigment epithelium (RPE) elevation. In the fellow eye, no RPE elevation or fluid was observed, but scattered drusen could be observed (Figure 1).

Figure 1. Right eye (top) and left eye (bottom) OCT scans showed slight RPE elevation OD and scattered drusen OU.
By the time he presented to my clinic, the patient’s VA had dropped to 20/60 OD. OCT imaging of that eye showed significant subretinal hyperreflective material (SHRM) centrally, with some subretinal fluid overlying the RPE elevation he’d had before (Figure 2, top). Vertical OCT cuts revealed more fluid pooling inferiorly compared to the superior macula (Figure 2, bottom).

Figure 2. OCT imaging of the right eye using horizontal OCT cuts (top) and vertical OCT cuts (bottom) at the time of presentation. VA OD was 20/60, and significant subretinal hyperreflective material and subretinal fluid was observed.
Using tools like Zeiss Retina Workplace helps me compare B-scans over time and track changes more effectively (Figure 3). It’s also great for patient education, as I could quickly show the patient a side-by-side comparison of their anatomy over time. Subretinal fluid in the inferior macula led me to suspect choroidal neovascularization (CNV), so I turned to OCTA to further investigate vascular structure. Sure enough, OCTA imaging confirmed my suspicion by depicting flow under the RPE elevation, which explained the SHRM and fluid (Figure 4).

Figure 3. Using ZEISS Retina Workplace, a vertical OCT image from 1 year prior to presentation (left) and at presentation (right) highlights the stark differences and progression to a mixed type neovascular lesion that is exuding.

Figure 4. OCTA imaging revealed flow beneath the elevated RPE, confirming a flow signal under the RPE and under the retina (mixed-type neovascularization).
The patient started on bevacizumab (Avastin, Genentech) treatment, later switching to aflibercept (Eylea, Regeneron). Unfortunately, he needed injections every 4 to 6 weeks for a long time to clear the fluid and improve the SHRM.
After 1 year of treatment, OCT showed significant improvement: SHRM and subretinal fluid resolved, but RPE elevation remained. I find it helpful to show patients their imaging progress over time, especially when they’re fatigued by frequent injections. Seeing how far they’ve come can be reassuring and reinforces the benefits of treatment (Figure 5).

Figure 5. OCT imaging showed resolved disease activity after 1 year of anti-VEGF therapy. Using ZEISS Retina Workplace, I could easily show the patient OCT images at baseline (left column), at presentation (center column), and after 1 year (right column) of treatment, which facilitates a conversation on response to treatment.
Yasha Modi, MD: What guides your choice between fluorescein angiography (FA) and OCTA for CSR or age-related macular degeneration (AMD)?
Dr. Talcott: I’ve shifted toward OCTA for many patients. It’s less invasive and more accessible in satellite clinics, where logistical challenges often limit FA availability. OCTA provides crucial insights, especially when differentiating between CNV and degenerative fluid in AMD or CSR.
Dr. Modi: Agreed. OCTA has revolutionized how we identify Type 1 neovascularization without fluid. I would note that the concept of identifying neovascularization without fluid was initially discovered with ICG testing,1 but in the era of OCTA, this diagnosis is easier to detect, and more retina specialists are using this nomenclature. Its ability to confirm neovascularization without fluid is invaluable, particularly in cases with pigment epithelial detachment.
Dr. Talcott: That said, OCTA has limitations. It requires stable fixation, making it challenging for patients with tremors or poor vision. Artifact-prone images may complicate interpretation, especially in elderly eyes or those with physical constraints.
Dr. Modi: Do you use OCTA for longitudinal monitoring?
Dr. Talcott: Occasionally, in eyes with persistent fluid or concerns about CNV development. While I haven’t seen cases where OCTA detected new CNV over time, it’s a convenient adjunct to routine imaging.
Dr. Modi: Similarly, I haven’t observed significant management changes based on longitudinal OCTA. However, it’s fascinating to track the evolution of Type 1 neovascularization. Neovascular type 1 lesions don’t regress in response to anti-VEGF therapy; rather, they become more complex and mature over time. High-quality imaging with swept-source OCTA on platforms further enhances our understanding.
Dr. Talcott: Absolutely. Swept-source OCTA delivers stunning visualizations, providing a deeper understanding of these lesions and their response to treatment.
Using OCTA to Differentiate RVO and RAO for Better Outcomes
Yasha Modi, MD: I want to highlight two cases that demonstrate the key differences between retinal vein occlusion (RVO) and retinal artery occlusion (RAO), as their implications and management vary significantly. RVO is often linked to hypertension and hyperlipidemia, whereas RAO can indicate a risk of embolic stroke or signal vasculitic diseases such as giant cell arteritis—both with serious consequences. While acute-stage signs make differentiation quite easy, it becomes much harder once the fundus appears bland in the chronic stages.
In the first case, a 55-year-old hypertensive patient presented with 20/100 vision. OCT imaging showed severe and widespread inner retinal thinning at a horizontal slice inferior to the fovea (Figure 6). Without acute findings, I turned to OCTA, which I favor for its ability to reveal vascularization and collateral development, especially along the border of the perfused and nonperfused retina. OCTA imaging showed significant macular nonperfusion, a hallmark feature of branch RVO (BRVO) with collaterals crossing the raphe (Figure 7). Here, OCTA imaging was essential in explaining the vision loss when OCT alone wasn’t enough to differentiate between branch RAO (BRAO) versus BRVO.
Figure 6. OCT inferior to the fovea showed significant retinal thinning in a 55-year-old patient who presented with 20/100 VA. Still, I was unable differentiate between BRAO versus BRVO by OCT imaging alone.

Figure 7. OCTA imaging showed significant macular nonperfusion with extensive collateralization at the margin of perfused and nonperfused retina, a hallmark sign of BRVO.
The second case involved a 66-year-old woman with hypertension, proliferative diabetic retinopathy (PDR), and coronary artery disease. She had classic PDR findings, including dot-blot hemorrhages and prior panretinal photocoagulation. Initial OCT revealed focal areas of middle retinal layer thinning which has been defined as retinal ischemic perivascular lesions (also called RIPLs) and represents focal dropout of the deep capillary plexus, but scrolling through the cube revealed diffuse inner retinal loss superior to the fovea. This pattern didn’t resemble typical microvascular disease and represented an area of more global ischemic injury.
I performed an OCTA, which showed diffuse loss of the superficial and deep capillary plexuses with no collateral vessels, consistent with a BRAO, a condition that she was not previously diagnosed (Figure 8). I recommended a carotid ultrasound and cardiac echocardiogram. Unfortunately, the patient was lost to follow-up. She returned 3 years later in a wheelchair with left hemiplegia following a right cerebrovascular accident (CVA). The early warning sign of a BRAO which carries an incrementally increased risk of CVA was evident when I first saw her.

Figure 8. On OCTA, this patient showed diffuse loss of the superficial capillary and deep capillary plexus, which is consistent with BRAO. This had not previously been diagnosed. Recognition of diffuse inner retinal thinning (not consistent with PDR alone) and obtaining an OCTA helped nail the diagnosis of a BRAO in the setting of PDR.
These cases highlight how OCTA can be instrumental in distinguishing RVO from RAO, especially when acute findings have resolved. Beyond aiding diagnosis, this technology can guide life-saving interventions by identifying underlying systemic risks that demand urgent attention.
Katherine Talcott, MD: We both teach residents and fellows. How do you teach your residents and fellows to use OCTA in such cases to improve their clinical skills?
Dr. Modi: When it comes to inner retinal problems, the answer often lies in a thorough clinical exam. One key distinction is that RVOs cause collateralization, whereas RAOs do not. OCTA highlights these differences, transforming what might be a difficult clinical exam into something much more straightforward.
Dr. Talcott: Differentiating between an RVO and an RAO isn’t just academic; it has real consequences. In the RAO case you presented, the patient developed further complications. Have you seen other instances where OCTA findings led to more in-depth workups than might otherwise have occurred?
Dr. Modi: Absolutely. When one sees signs of a BRAO, it is easy to assume that the patient is already medically optimized. My response is often that we don’t know that for sure. This is where retina specialists need to act as quarterbacks for the patient’s care. We understand aspects of the condition that other specialists, like cardiologists or neurologists, might overlook. A BRAO or central RAO significantly increases the risk of a stroke. I advocate for carotid ultrasounds, cardiac echoes, and sometimes even a 30-day Holter monitor or implantable 3-year loop recorder to detect paroxysmal atrial fibrillation. In vascular cases like the one we discussed, a carotid ultrasound alone could yield critical answers.
Dr. Talcott: As retina specialists, we often focus on the eyes, but the retina gives us insight into systemic health. We have the unique opportunity to impact a patient’s overall outcome.
Conclusion
As we move into 2025, the role of OCTA may very well expand in retina clinics. The more retina specialists know about OCTA, the more they can employ this technology in the most effective scenarios. Keep up with the latest conversations in retina—covering imaging and beyond—by tuning into New Retina Radio.
1. Nakajima M, Shimada H, Sato M, Asayama N, Yuzawa M. Indocyanine green angiography and histopathology of choroidal neovascular membrane in age-related macular degeneration. Jpn J Ophthalmol. 2000;44(4):360-367.
Interested in the rest of this discussion from Drs. Modi and Talcott? Visit New Retina Radio.
The statements of the speakers reflect only their personal opinions and experiences and do not necessarily reflect the opinion of any institution that they are affiliated with. The speakers alone are responsible for the content of their experience reported and any potential resulting infringements. Carl Zeiss Meditec AG and its affiliates do not have clinical evidence supporting the opinions and statements of the speakers nor accept any responsibility or liability of the speakers' content.


